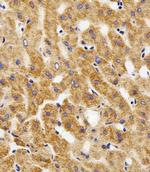
MPP7 Antibody in Immunohistochemistry (Paraffin) (IHC (P))
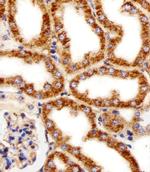
MPP7 Antibody in Immunohistochemistry (Paraffin) (IHC (P))
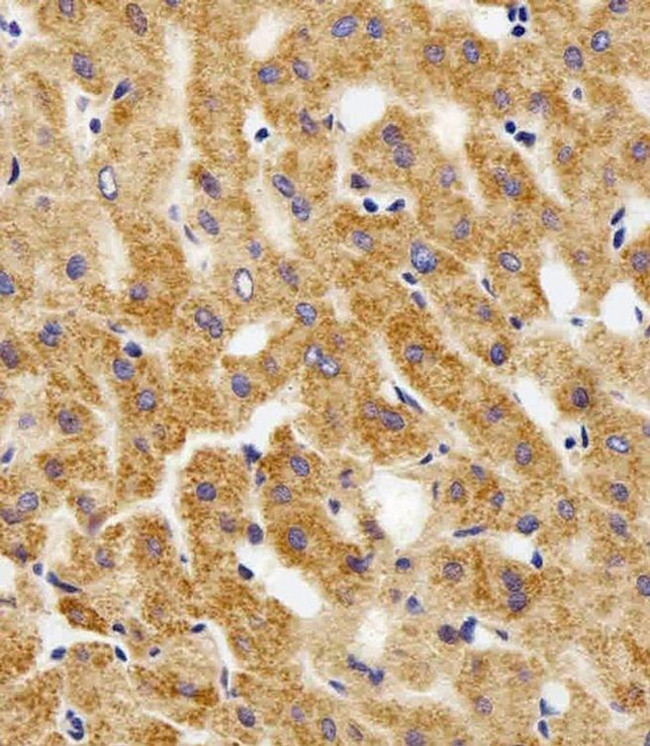
MPP7 Antibody in Immunohistochemistry (Paraffin) (IHC (P))

Search
Invitrogen
MPP7 Polyclonal Antibody
{{$productOrderCtrl.translations['antibody.pdp.commerceCard.promotion.promotions']}}
{{$productOrderCtrl.translations['antibody.pdp.commerceCard.promotion.viewpromo']}}
{{$productOrderCtrl.translations['antibody.pdp.commerceCard.promotion.promocode']}}: {{promo.promoCode}} {{promo.promoTitle}} {{promo.promoDescription}}. {{$productOrderCtrl.translations['antibody.pdp.commerceCard.promotion.learnmore']}}
Additional Information:
{{banner.description}}
图: 1 / 5
MPP7 Antibody (PA5-49335) in IHC (P)
Immunohistochemical analysis of MPP7 in paraffin-embedded Human liver section. Samples were incubated using MPP7 Antibody (N-term) (Product # PA5-49335) at a 1:100 dilution, followed by a peroxidase-conjugated goat anti-rabbit IgG at 1:400 dilution was used as the secondary antibody, followed by DAB staining.

产品信息
PA5-49335
产品规格
宿主/亚型
Rabbit
/ IgG
分类
Polyclonal
类型
Antibody
抗原
KLH conjugated synthetic peptide between 2-36 amino acids from the N-terminal region of human MPP7.
偶联物
形式
Liquid
浓度
Lot-Specific
保存条件
-20°C, Avoid Freeze/Thaw Cycles
运输条件
Wet ice
RRID
靶标信息
Acts as an important adapter that promotes epithelial cell polarity and tight junction formation via its interaction with DLG1. Involved in the assembly of protein complexes at sites of cell-cell contact.
仅用于科研。不用于诊断过程。未经明确授权不得转售。
篇参考文献 (0)
您是否在文献中引用过该产品?请点击下方按钮邮件告知我们。